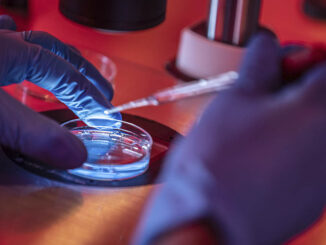

🔊 Muestra Programa de Maternidad y Paternidad Consciente resultados satisfactorios en Granma (+ audio)
En el Hospital General Provincial Carlos Manuel de Céspedes de Bayamo se desarrolla el Programa de Maternidad y Paternidad Consciente con el objetivo de preparar física y psicológicamente a las embarazadas para el parto.